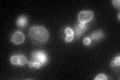
YLL048C
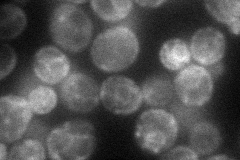
YLL048C
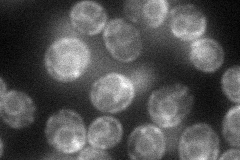
YLL048C
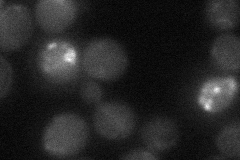
YLL048C

View description
Transporter of the ATP-binding cassette (ABC) family involved in bile acid transport; similar to mammalian bile transporters
Localization:
Intensity:
Fold change:
Significance:
-
C’ GFP library in SD
vacuole membrane50.09 -
N' NOP1pr-GFP in SD
ER51.404 -
N' TEF2pr-mCherry in SD
ER47.0545 -
N' NATIVEpr-GFP in SD

below threshold18.8908 -
N' TEF2pr-VC and Cyto-VN in SD
below threshold24.1334 -
C’ GFP library in SD+DTT

vacuole membrane44.650.89No -
C’ GFP library in SD+H2O2

vacuole membrane50.551No -
C’ GFP library in Starvation Media

vacuole membrane46.470.92No -
C’ GFP library on the background of Pup2-DaMP

N/A -
C’ GFP library on the background of CCT mutant

N/A0N/AYes
